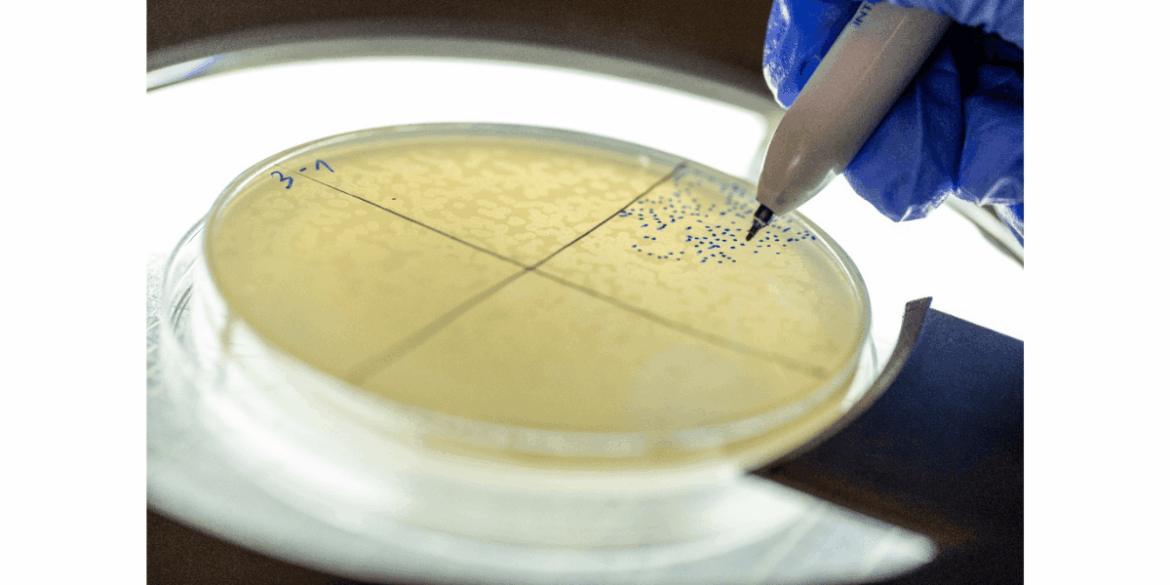
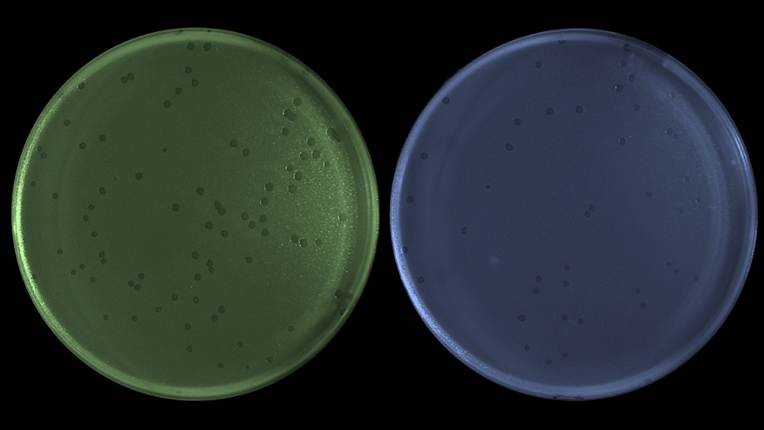
A close up of a green and blue circleAI-generated content may be incorrect.
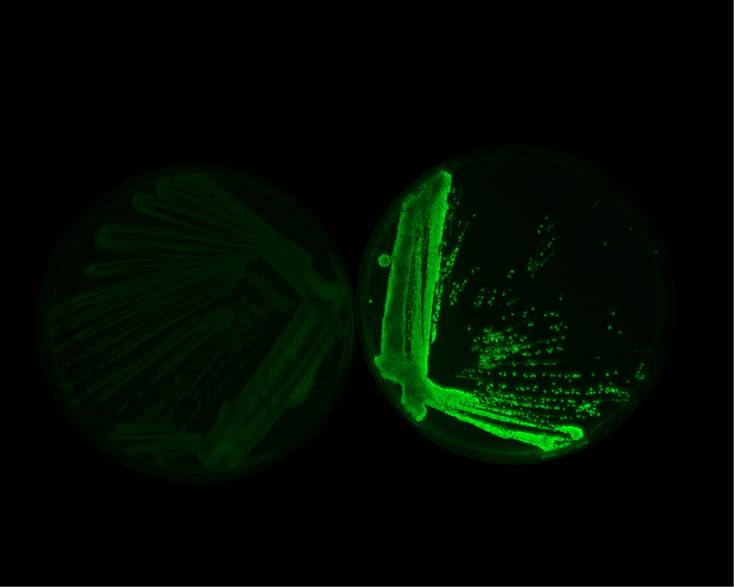

As antibiotic-resistant infections rise and are projected to cause up to 10 million deaths per year by 2050, scientists are looking to bacteriophages, viruses that infect bacteria, as an alternative. A new study shows how these phages use a tiny RNA molecule, called PreS, to hijack bacterial cells and boost their own replication. By acting as a hidden genetic “switch” that rewires key bacterial genes, PreS helps the virus copy its DNA more efficiently, offering important insights that could guide the design of smarter phage-based therapies.
Title Image: Phage plaques on an E. coli culture, counted by Adi Levkowitz. Credit: Yosef Adest
A new study from the Hebrew University of Jerusalem reveals how viruses that infect bacteria, called bacteriophages or “phages,” use a tiny piece of genetic material to hijack bacterial cells and make more copies of themselves.
The research shows that a very small RNA molecule, called PreS, acts like a hidden “switch” inside the bacterial cell. By flipping this switch, the virus can change how the bacterial cell works and push the infection forward.
Antibiotic resistance is one of the biggest global health threats of our time. It is currently estimated that by 2050, infections caused by antibiotic-resistant bacteria could kill up to 10 million people every year worldwide. One promising alternative being developed is phage therapy, using viruses that specifically attack bacteria instead of relying only on antibiotics.
By uncovering how phages use tools like PreS to take control of bacterial cells, this study provides important basic knowledge that could help scientists design smarter, more effective phage treatments in the future.
A Viral Micro Manager
The research team at the Hebrew University, led by Dr. Sahar Melamed, PhD student Aviezer Silverman, MSc student Raneem Nashef, and computational biologist Reut Wasserman, in collaboration with Prof. Ido Golding from the University of Illinois Urbana-Champaign discovered that the phage makes a small RNA molecule called PreS that acts as a molecular switch.
Until now, most phage research has focused on viral proteins. This study shows that phages also use RNA molecules to quickly reprogram the host cell after the bacterial genes have already been read and bacterial messages (mRNAs) were made, adding an extra layer of control during infection.
PreS attaches to these important bacterial messages and tweaks them in a way that helps the virus copy its DNA and move more efficiently toward the stage where new viruses are produced and burst out of the cell, killing the bacterium.
Using advanced methods to map RNA–RNA interactions (termed RIL-seq), the researchers found that one of PreS’s key targets is a bacterial message that makes DnaN, a protein that plays a central role in copying DNA. By helping the cell make more DnaN, PreS gives the virus a strong head start in the infection process.
Cutting through the cell’s defenses
Interestingly, PreS works by changing the shape of the bacterial dnaN message.
Normally, part of this message is tightly folded, which makes it hard for the cell’s protein-making machines (ribosomes) to access. PreS binds to this folded region, opens it up, and allows ribosomes to read and translate the message more efficiently.
The result: more DnaN protein, faster viral DNA copying, and a stronger infection. When the researchers removed PreS or disrupted the spot where it binds, the phage became weaker, multiplied more slowly, and its destructive phase was delayed.
A window into a new class of viral tools
This discovery is particularly striking because small RNAs have not traditionally been seen as major players in phage biology. Yet PreS is highly conserved in many related viruses, suggesting that phages may share a common “toolkit” of small RNAs that scientists are only beginning to uncover.
“This small RNA gives the phage another layer of control,” says Dr. Sahar Melamed. “By regulating essential bacterial genes at exactly the right moment, the virus improves its chances of successful replication. What astonished us most is that phage lambda, one of the most intensively studied viruses for more than 75 years, still hides secrets. Discovering an unexpected RNA regulator in such a classic system suggests we have only grasped a single thread of what may be an entirely richer, more intricate tapestry of RNA-mediated control in phages.”
Looking ahead: toward better phage therapies
Understanding how phages control bacterial cells is crucial for both basic science and future medical applications. As the world searches for solutions to antibiotic-resistant infections, phages are drawing growing interest as a targeted, flexible therapy.
Discoveries like PreS show that even the smallest viral molecules can have a big impact on whether an infection succeeds. In the long term, this knowledge could help researchers engineer phages that are safer, more predictable, and more powerful in the fight against drug-resistant bacteria.
Description: Reduced phage propagation on an E. coli culture with phage lambda carrying a non-functional PreS small RNA (blue) in comparison to wild-type phage lambda (green). Plates are artificially colored. Credit: Aviezer Silverman
Description: Bacteria expressing the viral small RNA PreS (right) show stronger fluorescence, indicating increased activity of a bacterial gene regulated by PreS, compared with bacteria that do not express the RNA (left). Credit: Aviezer Silverman
Description: Bacteria expressing the viral small RNA PreS (top) show stronger fluorescence, indicating increased activity of a bacterial gene regulated by PreS, compared with bacteria that do not express the RNA (bottom). Credit: Aviezer Silverman

The research paper titled “Phage-encoded small RNA hijacks host replication machinery to support the phage lytic cycle” is now available in Molecular Cell and can be accessed at https://doi.org/10.1016/j.molcel.2025.11.019
Researchers:
Aviezer Silverman, Raneem Nashef, Reut Wasserman, Tamar Noy, Susan Born, Tianyou Yao, Yuncong Geng, Hila Rotbard, Adi Levkowitz, Yotam Kaufman, Ido Golding, and Sahar Melamed
Institutions:
- Department of Microbiology and Molecular Genetics, Institute for Medical Research Israel-Canada, Faculty of Medicine, The Hebrew University of Jerusalem
- Department of Physics, University of Illinois Urbana-Champaign
- Center for Biophysics and Quantitative Biology, University of Illinois Urbana-Champaign
- Department of Microbiology, University of Illinois Urbana-Champaign